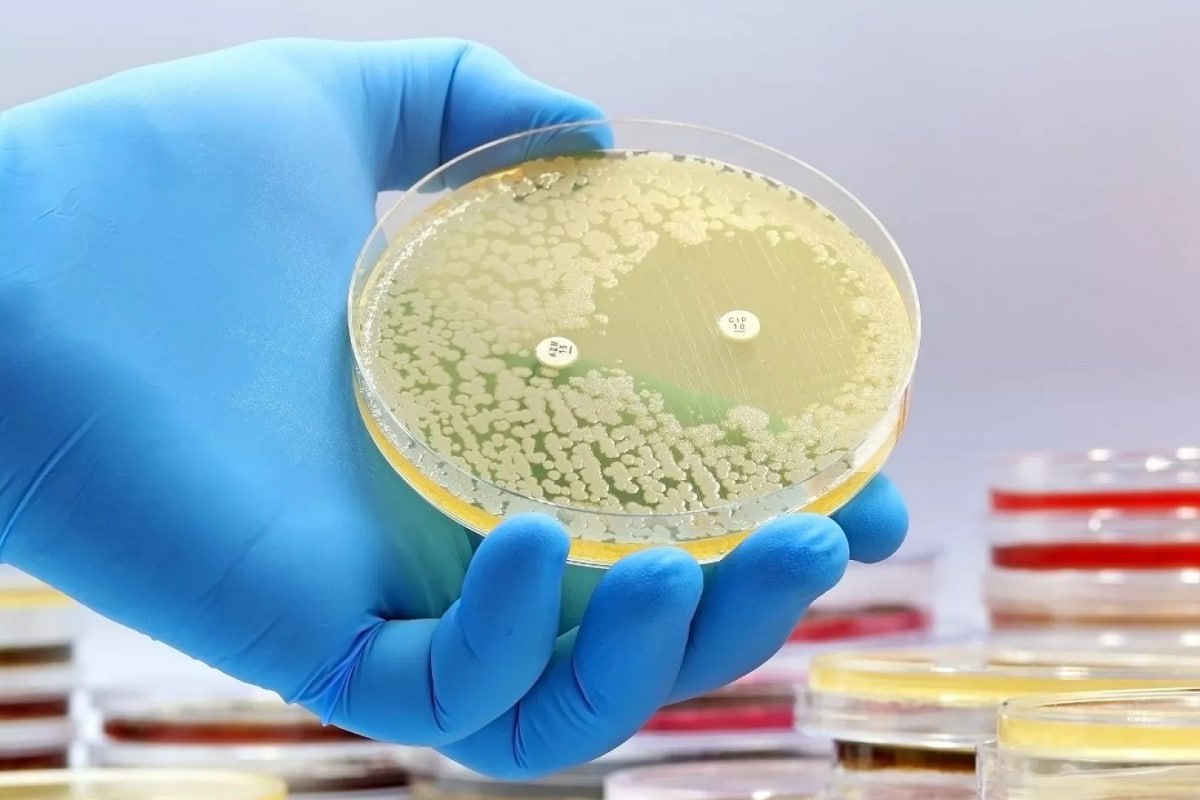
دوای تێپەڕبوونی ٦٠ ساڵ " ئانتی بایۆتیکێکی " دژە زیندەیی نوێ دۆزرایەوە

لە تانجەرۆ شوێنەوارێک دۆزرایەوە بۆ 2500 ساڵ پێش زایین دەگەڕێتەوە

پەیامی کورد... لە تانجەرۆ شوێنەوارێک دۆزرایەوە بۆ 2500 ساڵ پێش زایین دەگەڕێتەوە
لە سنووری ناحیەی تانجەرۆ شوێنەوارێکی مێژوویی دۆزرایەوە کە بۆ زیاتر لە 2 هەزار و 500 ساڵ پێش زایین دەگەڕێتەوە.
پەیجی پارێزگای سلێمانی بڵاویکردووەتەوە، دوای هەفتەیەک کنە و پشکنین، تیمێکی هاوبەشی شوێنەواری سلێمانی و زانکۆی چوبۆ، شوێنەوارێکی گرنگیان لە گردی یاسین تەپەی سنووری ناحیەی تانجەرۆ دۆزییەوە، کە مێژووەکەی دەگەڕێتەوە بۆ زیاتر لە 2500 پێش زایین.
ئەوەش هاتووە، کاری کنە و پشکنین لە شوێنەوارەکەدا بە هاوبەشی هەر دوو شوێنەوارناس و شارەزایانی بەڕێوەبەرایەتی شوێنەواری سلێمانی و تیمی زانکۆی چوبۆی ژاپۆنی بە سەرۆکایەتیی پڕۆفیسۆر "شین نیشیاما" بەڕێوەدەچێت.
لای خۆیەوە د. هەڤاڵ ئەبووبەکر پارێزگاری سلێمانی ئاماژەی بەوەداوە، کارکردنی تیمەکان لە ماوەی هەفتەیەکدا، بەرهەمی زۆر باشی هەبووە و شتی دەگمەن و گرنگ لە شوێنەوارەکەدا دۆزراونەتەوە کە هاوشێوەیان لە عێراق و کوردستاندا نییە.
بەپێی زانیارییەکان، مێژووی شوێنەوارەکە لە سەردەمی چاخی بەردینی نوێوە دەست پێدەکات تاوەکوو سەردەمی ئیسلامی، کە تێیدا پاشماوەی بینا و کۆڵان و شوێنی ناشتنی مردووان دەرکەوتووە.

هێشتا لێدوان نییە. یەکەمین لێدوان بنووسە!
لێدوانی خۆت بنووسە